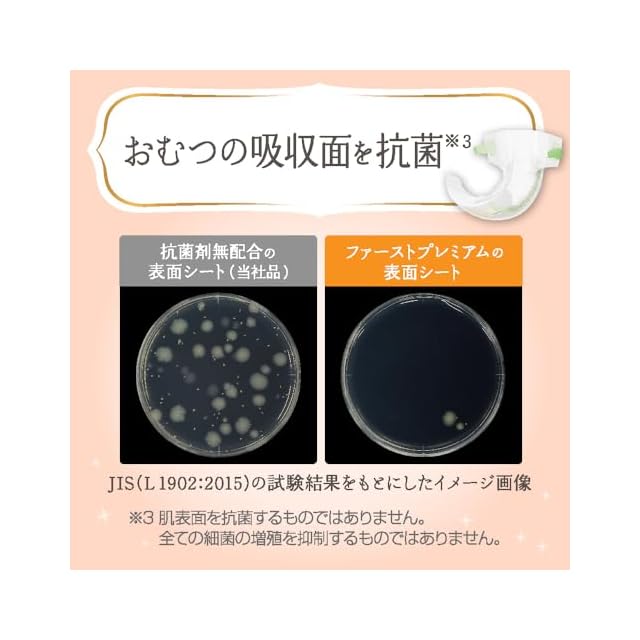

1/8
メリーズ 【テープ Sサイズ】 ファーストプレミアム(4~8kg) 216枚 (54枚×4) [ケース品] 【.co.jp限定】
¥7,845
International shipping available
【商品概要】
繊細な肌に5ッ星のやさしさを。伸縮性のギャザーで、足まわりもすきまモレ安心。
テープS【4~8kg】
【商品詳細】
ブランド:メリーズ
商品種別:使い捨てベビーおむつ
商品名:メリーズ 【テープ Sサイズ】 ファーストプレミアム(4~8kg) 216枚 (54枚×4) [ケース品] 【.co.jp限定】
製造元:花王
発売日:2025年05月16日
商品内容:新)216枚
色:ライトピンク
梱包サイズ:120.4cm
-
レビュー
(86)
最近チェックした商品
その他の商品